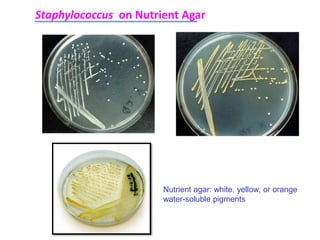
Staphylococcus on Nutrient Agar
Nutrient agar: white, yellow, or orange
water-soluble pigments

Staphylococcus is a genus of gram-positive, non-motile cocci arranged in grape-like clusters, commonly found on the skin and mucous membranes of mammals and birds. They possess various virulence factors and are known for causing several infections, including bovine mastitis and pyoderma in pets. Diagnosis involves culture methods, biochemical tests, and antimicrobial treatments may vary, with resistance being a significant concern.